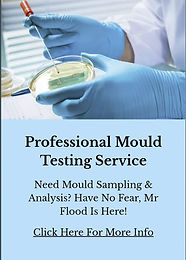
IMG-20250311-WA0059.jpg

Trauma & Biohazard Cleaning Services
Have No Fear, Mr Flood Is Here!
Specialist Cleaning for Hazardous Environments
Certain environments - such as crime scenes, unattended deaths, and hazardous contamination sites require specialist cleaning due to the presence of biohazards. Our team is fully trained and certified to decontaminate and restore affected areas safely and discreetly.
The Importance of Professional Biohazard Cleanup
🟡 Eliminates Health Risks – Bloodborne pathogens and harmful bacteria must be removed safely.
🟡 Complies with Legal & Safety Regulations – Improper cleaning can lead to legal liabilities.
🟡 Restores Liveability – Making spaces safe for future use.
🟡 Provides Discreet & Compassionate Service – Respectful handling of sensitive situations.
Our Biohazard Cleaning Services
🩸 Crime Scene & Trauma Cleanup – Removing blood and bodily fluids.
🩸 Sewage & Flood Remediation – Eliminating hazardous waste.
🩸 Drug Lab, Sharps & Needle Sweeps – Ensuring environments are safe.
🩸 Animal Waste & Hoarding Cleanup – Restoring hygienic conditions.
Need Specialist Biohazard Cleaning?